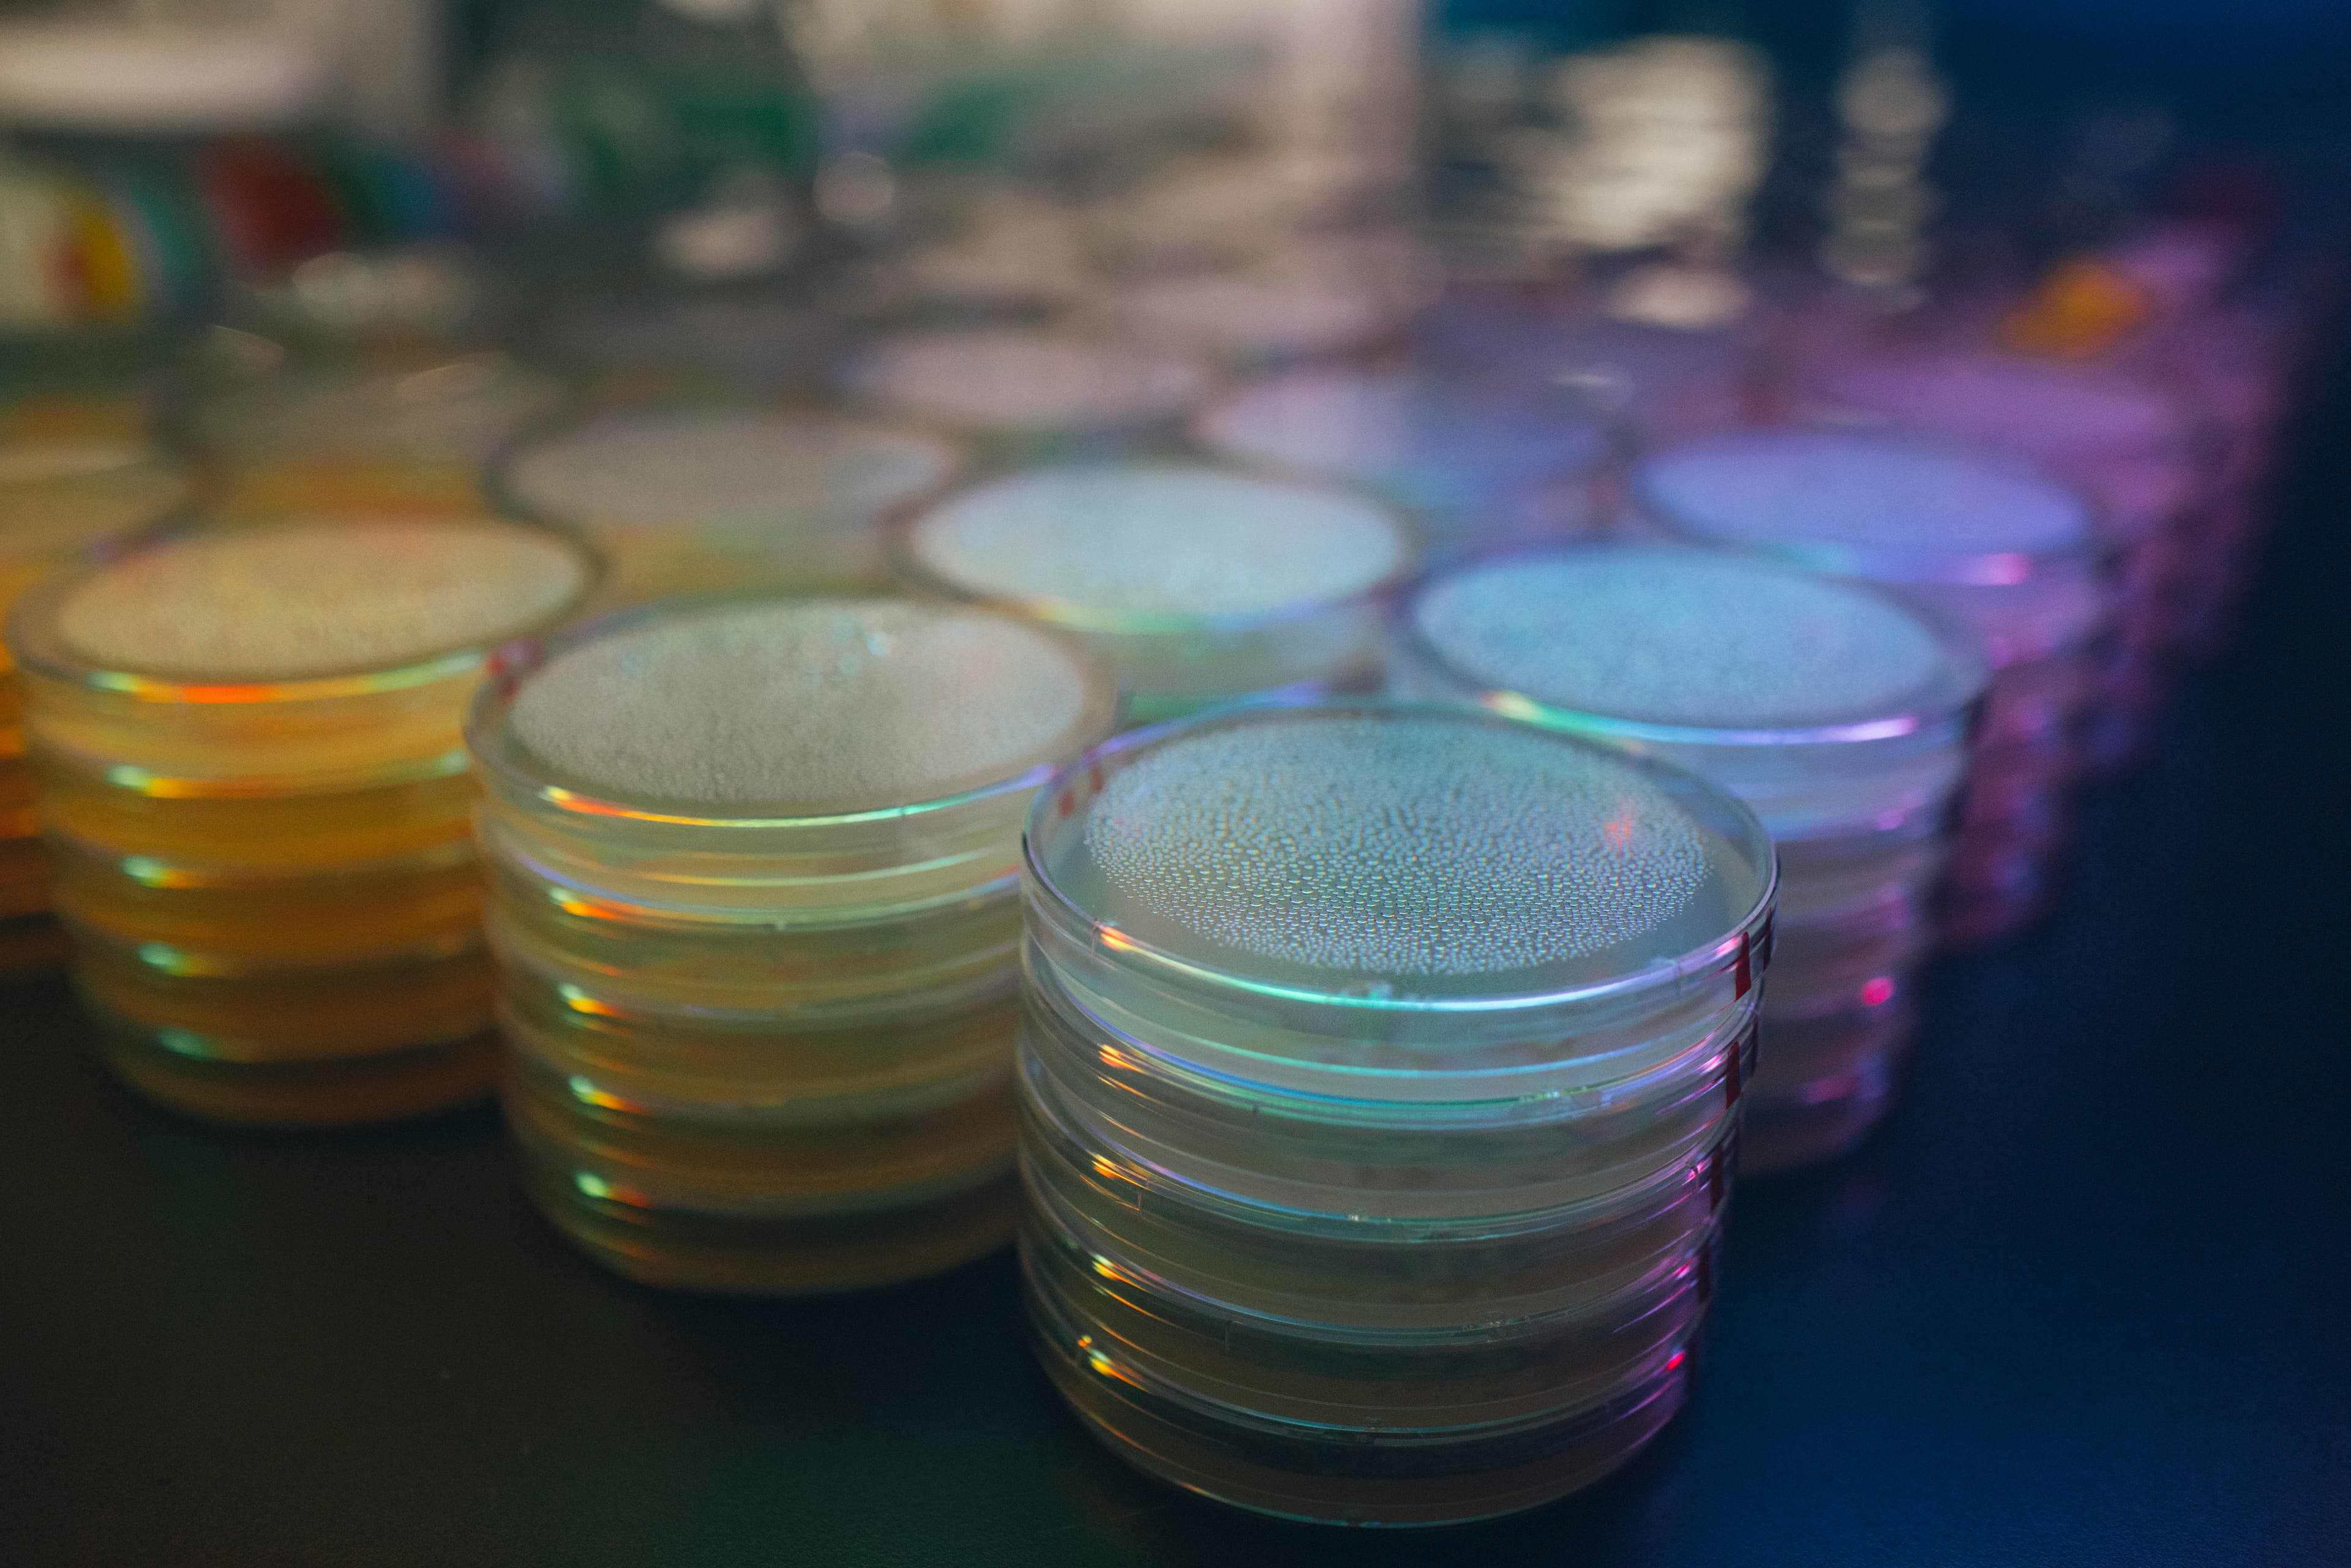

about
Imagine a world where disease reversal is possible

A New Model
Scientific freedom focused on making medicines

Discovery Engine
Designed to unite great minds

Computation
A powerful computational ecosystem
Translation
Translating breakthrough science into breakthrough medicines
People
Guided by pioneers in science and industry
Executive Leadership
Search people

Hal Barron
CEO and Founder
Hal Barron
CEO and Founder
Rick Klausner
Chief Scientific Advisor and Founder
Hans Bishop
President and Founder
Juan Carlos Izpisua Belmonte
Founding Scientist and Senior Vice President
Kevin Sin
Chief Financial and Business Officer
Wolf Reik
Director, Cambridge Institute of Science
Jodi Nunnari
Director, Bay Area Institute of Science
Hana El-Samad
SVP and Director, Institute of Computation
Thore Graepel
Distinguished Fellow, Artificial Intelligence and Machine Learning
Laurie Hill
General Counsel and Chief Compliance Officer
Connie White
Chief People Officer
Danielle Morris
VP, Strategic Partnerships
Hal Barron
CEO and Founder
Rick Klausner
Chief Scientific Advisor and Founder
Hans Bishop
President and Founder
Juan Carlos Izpisua Belmonte
Founding Scientist and Senior Vice President
Kevin Sin
Chief Financial and Business Officer
Wolf Reik
Director, Cambridge Institute of Science
Jodi Nunnari
Director, Bay Area Institute of Science
Hana El-Samad
SVP and Director, Institute of Computation
Thore Graepel
Distinguished Fellow, Artificial Intelligence and Machine Learning
Laurie Hill
General Counsel and Chief Compliance Officer
Connie White
Chief People Officer
Danielle Morris
VP, Strategic Partnerships
Board of Directors
Scientific Advisor

Shinya Yamanaka
Senior Scientific Advisor
Institutes of Science
Pursue deep scientific questions and integrate findings to advance progress towards our mission.

Peter Walter
Bay Area Institute
Peter Walter
Bay Area Institute
Diego Acosta-Alvear
Bay Area Institute
Jin Chen
Bay Area Institute
Mauro Costa-Mattioli
Bay Area Institute
Adam Frost
Bay Area Institute
Susanna Rosi
Bay Area of Institute
Maria Abad
Cambridge Institute
Robin Franklin
Cambridge Institute
Steve Horvath
Cambridge Institute
Delphine Larrieu
Cambridge Institute
Giovanna Mallucci
Cambridge Institute
Ken Raj
Cambridge Institute
Manuel Serrano
Cambridge Institute
Zachary Levine
San Diego Institute
Pura Muñoz-Cánoves
San Diego Institute
Kun Zhang
San Diego Institute
Peter Walter
Bay Area Institute
Diego Acosta-Alvear
Bay Area Institute
Jin Chen
Bay Area Institute
Mauro Costa-Mattioli
Bay Area Institute
Adam Frost
Bay Area Institute
Susanna Rosi
Bay Area of Institute
Maria Abad
Cambridge Institute
Robin Franklin
Cambridge Institute
Steve Horvath
Cambridge Institute
Delphine Larrieu
Cambridge Institute
Giovanna Mallucci
Cambridge Institute
Ken Raj
Cambridge Institute
Manuel Serrano
Cambridge Institute
Zachary Levine
San Diego Institute
Pura Muñoz-Cánoves
San Diego Institute
Kun Zhang
San Diego Institute
Institute of Medicine
Capture knowledge about cell health and programming and develop transformative medicines.

Dolo Diaz
Global Head and SVP of Discovery and Development Sciences
Institute of Computation
To build computational models that decode the language of biological resilience.

Hana El-Samad
SVP and Director, Institute of Computation